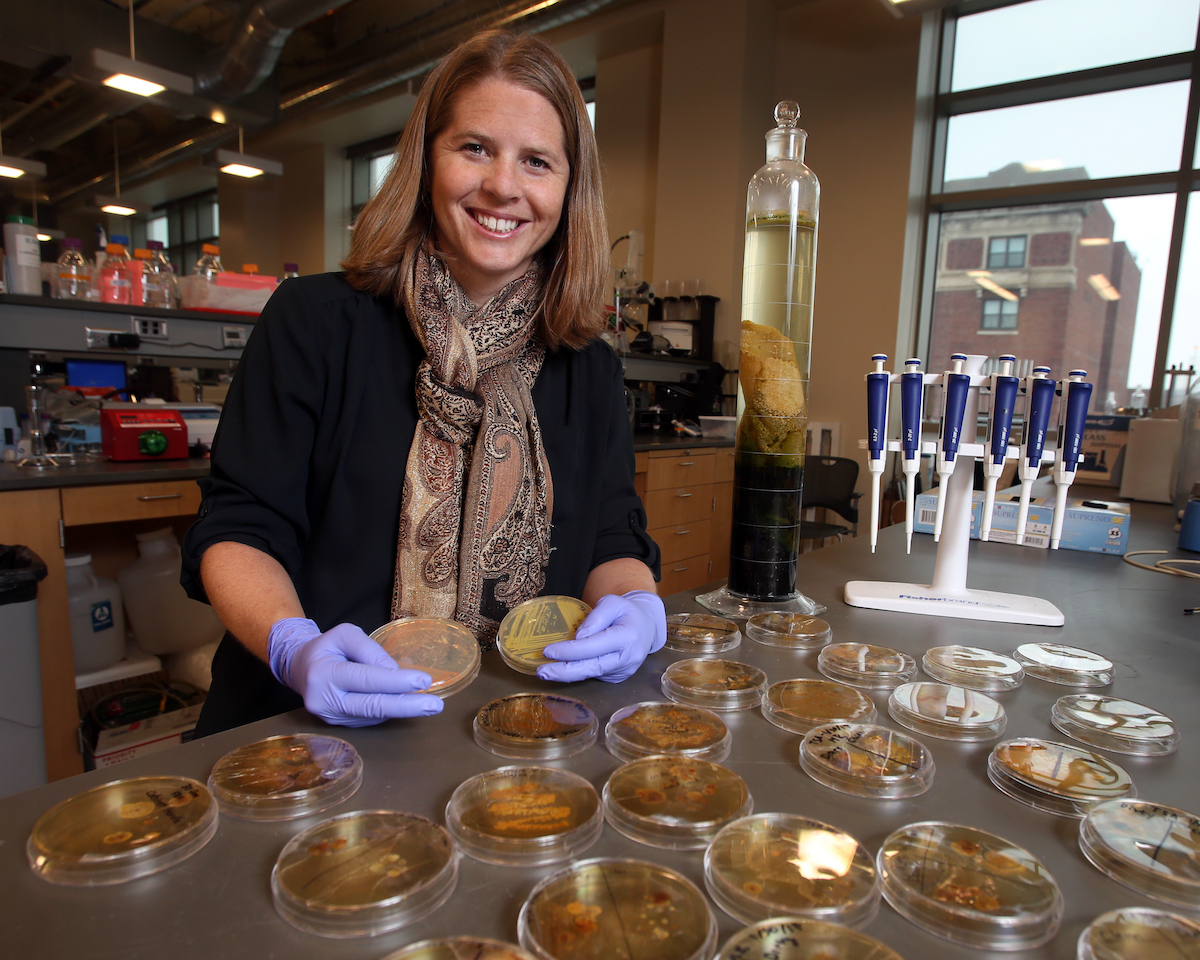

Marquette engineering professor partners with NSF center for phosphorus sustainability
Oct. 21, 2021
 MILWAUKEE — Dr. Brooke Mayer, associate professor of civil, construction and environmental engineering in Marquette University’s Opus College of Engineering, has received a $627,000 subaward as a partner in the National Science Foundation Science and Technology Center – Science and Technologies for Phosphorus Sustainability (STEPS), a five-year, $25 million initiative led by North Carolina State University.
MILWAUKEE — Dr. Brooke Mayer, associate professor of civil, construction and environmental engineering in Marquette University’s Opus College of Engineering, has received a $627,000 subaward as a partner in the National Science Foundation Science and Technology Center – Science and Technologies for Phosphorus Sustainability (STEPS), a five-year, $25 million initiative led by North Carolina State University.
Mayer is partnering with NCSU, which will serve as the STEPS headquarters, as well as seven other institutions around the country. STEPS is a national research effort to reduce both dependence on mined phosphates and the amount of phosphorus that leaches into soil and water. STEPS has ambitious goals to facilite a 25% reduction in human dependence on mined phosphates and a 25% reduction in phosphorus losses to soils and water resources within 25 years, leading to enhanced resilience of food systems and reduced environmental damage.
“We are absolutely thrilled to be working together as part of this team of phosphorus experts in pursuit of a more sustainable future,” Mayer notes. “STEPS brings together 28 distinct disciplines to tackle ‘the phosphorus problem no one is talking about,’ with major implications for food security as well as environmental quality. Our convergence research approach brings together diverse investigators working across 17 orders of magnitude in length scale — from the atomic to global scales — to advance use-inspired basic research addressing this wickedly complex challenge.”
Mayer is serving on the center’s leadership team as co-director of education and human resources. She is also leading several interdisciplinary research projects, one of which focuses on bioinspired materials to remove phosphorus from water and subsequently recover it for beneficial reuse, such as fertilizer. In another project, Mayer and colleagues will explore chemical and biological transformations of complex phosphorus species, targeting improved understanding of pathways to improve phosphorus removal and recovery. These efforts, and the other STEPS projects, engage faculty as well as graduate and undergraduate student researchers from science and engineering disciplines across STEPS institutions.
“We are excited for Dr. Mayer as she has the opportunity to partner with a network of colleagues for an impactful study of phosphorus sustainability,” said Dr. Kristina Ropella, Opus Dean of the Opus College of Engineering. “We are proud of the contribution Brooke will make and the spotlight she will bring to the environmental engineering research being done at Marquette.”
The STEPS Center is a convergence research community of diverse scientists and engineers with collective expertise that addresses the complex challenges in phosphorus sustainability by integrating disciplinary contributions across the physical, life, social and economic sciences.
STEPS is one of six new Science and Technology Centers announced by NSF to advance ambitious, complex research in fields ranging from mechanobiology to particle physics to climate change. The centers focus on establishing new scientific disciplines and developing transformative technologies that have the potential for broad impacts on science and society. The Science and Technology Centers Integrative Partnerships program has supported research in areas of national importance since 1987.
About Kevin Conway

Kevin is the associate director for university communication in the Office of Marketing and Communication. Contact Kevin at (414) 288-4745 or kevin.m.conway@marquette.edu.
MILWAUKEE —
MILWAUKEE — 
